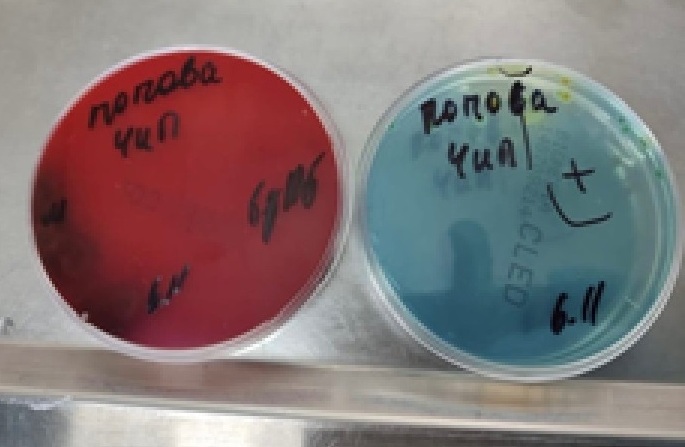
Рисунок 5_А Рисунок 5_А

Кашковская Л. М. – к.в.н., руководитель группы по исследованию лекарственных форм, ООО «НИТА-ФАРМ», г. Саратов.
Морозова А. М. – к.в.н., старший научный сотрудник по ветеринарии, ООО «НИТА-ФАРМ», г. Саратов.
Введение
На данный момент в ветеринарной медицине бактериальные заболевания мочевыделительной системы у животных-компаньонов представляют значительную проблему16. Согласно результатам современных исследований, распространенность данных патологий неуклонно растет и составляет около 14% в популяции собак и 20–30% у кошек среди всех патологий мочевыведения (высокие значения при ХБП и в гериатрический период)3,4,10,13. При этом особую тревогу вызывает высокая частота рецидивирующих, осложненных форм заболеваний, что в случае эмпирического или некорректного назначения антибактериальных препаратов не предотвращает проникновение уропатогенов в другие отделы мочевыводящей системы (например, восходящее инфицирование почек), а также способствует росту мультирезистентных микроорганизмов и ограничивает выбор этиотропной терапии11.Сложившаяся ситуация диктует необходимость в выборе наиболее активного и при этом безопасного антибактериального препарата, способного в кратчайшие сроки достичь полной эрадикации возбудителя.
В этом контексте азитромицин, относящийся к группе макролидных антибиотиков, демонстрирует ряд значительных преимуществ. Так, благодаря уникальным фармакокинетическим свойствам, включая тропность к тканям мочевыделительной системы и значительный постантибиотический эффект, обеспечиваются высокие концентрации азитромицина в очаге инфекции (многократно превышающие МИК основных уропатогенов) даже при относительно коротких курсах лечения1,9,14. Другим преимуществом азитромицина является его способность к внутриклеточному накоплению, что особенно актуально при лечении хламидийных и микоплазменных инфекций2,12. Важно отметить, что, кроме мощной антибактериальной активности, азитромицин обладает высоким профилем безопасности и имеет низкую частоту побочных эффектов по сравнению с некоторыми бета-лактамными антибиотиками или фторхинолонами6 7 8,15.
Приведенные фармакокинетические/фармакодинамические преимущества азитромицина и отсутствие лицензированных ветеринарных препаратов на его основе в форме таблеток для перорального приема послужили основаниями для разработки компанией «НИТА-ФАРМ» лекарственного препарата «Азитронит Солютаб», специально адаптированного под вкусовые предпочтения собак и кошек и с удобным дозированием для животных разных весовых категорий.
Для подтверждения эффективности препарата «Азитронит Солютаб» ниже приведены результаты его применения при заболеваниях органов мочевыделения бактериальной этиологии у собак и кошек.
Материалы и методы
Научно-исследовательская работа была проведена в период с августа по ноябрь 2023 г. на базе ветеринарных клиник города Москвы.На прием поступали самцы и самки собак (n = 8) и кошек (n = 8) в возрасте от 4 месяцев до 22 лет с жалобами владельцев на странгурию, поллакиурию, боль при пальпации мочевого пузыря.
При клиническом осмотре обнаружены императивный позыв к мочеиспусканию, дизурия и поллакиурия, гематурия, частичная невозможность мочеиспускания. Активность у особей до лечения была умеренной или несколько сниженной. Аппетит, прием корма и воды сохранены, в единичных случаях снижены, наблюдается болезненность при пальпации в области мочевого пузыря. Мочевой пузырь при сохранении эвакуации мочи не дилатирован.
Общий анализ мочи у собак (табл. 1) выявил наличие слизи, протеинурию (повышение уровня белка в 3 раза), гематурию (появление гемоглобина до 6,0 ± 3,93 ед/ поле зрения), повышение эритроцитов в 6 раз, лейкоцитов – в 9,2 раза, а также увеличение плоского эпителия и неорганического осадка (кристаллы трипельфосфатов). У кошек (табл. 2) также содержание белка в моче возрастало в 2,5 раза и составляло 0,74 ± 0,36 г/л, а лейкоцитов – в 3,4 раза; наблюдались гематурия (содержание эритроцитов в моче достигает значения 3,24 ± 1,75 эритр/мкл), кристаллурия (рис. 1, 2), увеличение плоского эпителия (в 5 раз).
У большинства животных гематологические показатели при нарушении мочевыделения в среднем находились в пределах нормы, однако на фоне бактериального поражения зафиксирован относительный нейтрофильный лейкоцитоз.
Ультразвуковое исследование (УЗИ). У животных с диагнозами «цистит» и «уроцистит» выявляли следующие изменения: мочевой пузырь лоцировался топографически правильно, имел овоидную форму. Его объем варьировался в зависимости от степени наполненности, при частичной обструкции мочеиспускательного канала объем остаточной мочи был увеличен. Содержимое пузыря анэхогенной природы, нередко с наличием мелкодисперсной взвеси различной эхогенности (рис. 3), стенка утолщена (рис. 4).
После анализа результатов исследований была подтверждена патология мочевыделительной системы (уролитиаз, уретрит, цистит). У животных не подтвердилось наличие другой сопутствующей патологии.
Для подтверждения бактериальной природы воспаления у больных собак и кошек до лечения провели бактериологическое исследование мочи (рис. 5).
По результатам исследования была выявлена микробная контаминация следующими культурами: Klebsiella spp., Micrococcus spp., Staphylococcus aureus, Escherichia coli, Enterococcus faecium, Streptococcus spp., Staphylococcus epidermidis (в основном в форме различных ассоциаций).
Терапия. В качестве этиотропной терапии применяли антибактериальный препарат «Азитронит Солютаб» перорально в дозе по азитромицину 10 мг/кг массы животного, 1 раз в сутки (на протяжении 5 суток). Лечение дополняли симптоматическими и патогенетическими средствами (спазмолитики, НПВП).
В период лечения за животными наблюдали для учета динамики клинического состояния. По завершении терапии (на 5-е сутки) осуществляли повторный осмотр и отбор мочи для лабораторных исследований. Об эффективности антибактериальной терапии судили по клиническому состоянию, купированию симптомов болезни и результатам общего и бактериологического анализов мочи. На основании полученных данных проводили оценку эффективности препарата на основе азитромицина при лечении бактериальных инфекций мочевыделительной системы у собак и кошек.
Результаты исследований
Пероральное введение препарата «Азитронит Солютаб» в дозе 10 мг/кг массы тела по действующему веществу (ДВ) на протяжении 5 суток способствовало нормализации состояния больных собак и кошек: активность улучшалась, аппетит и потребление корма соответствовали физиологической норме, мочеиспускание было регулярным и без крови, акты мочеиспускания непродолжительные и безболезненные, моча желтого или светло-желтого цвета.При пальпации живота в гипогастральной области и мочевого пузыря отсутствовали напряжение и болезненность. Мочевой пузырь умеренно наполнен или опустошен. У самок слизистая оболочка влагалища не гиперемирована, не увеличена в размерах, экссудат на ее поверхности отсутствует. У самцов слизистая оболочка препуция светло-красного или розового цвета, не увеличена в размерах, экссудат на ее поверхности отсутствует.
УЗИ после лечения у животных не выявило наличия патологий: мочевой пузырь овоидной формы лоцировался топографически правильно. Его объем варьировался в зависимости от степени наполнения мочой. Содержимое мочевого пузыря анэхогенной природы, мелкодисперсная взвесь, как правило, отсутствовала. Размер его стенки был меньше по сравнению с данными до лечения (рис. 6).
При повторном исследовании мочи (по окончании антибактериальной терапии) уровень белка снизился более чем в 3 раза и приблизился к верхней границе нормы 0,2 ± 0,1 г/л (р ≤ 0,05) по сравнению с данными первых суток исследования. Пероральное введение больным собакам и кошкам препарата «Азитронит Солютаб» нивелировало число белых кровяных клеток в моче к пятым суткам опыта до референтных значений (р ≤ 0,05) и способствовало достоверному купированию гематурии. Идентичная тенденция зафиксирована в отношении гемоглобина в моче и кристаллов (рис. 6) по сравнению с данными до лечения.
У собак и кошек на фоне 5-суточного перорального применения антибактериального препарата «Азитронит Солютаб» при повторном бактериологическом исследовании мочи не было выявлено патогенных микроорганизмов (рис. 7).
Анализируя результаты выполненной работы, можно отследить явную корреляцию между фармакодинамическими особенностями азитромицина и клиническими эффектами препарата «Азитронит Солютаб». Так, быстрое купирование симптомов заболеваний мочевыделительной системы у опытных животных опосредуется достижением высоких тканевых концентраций действующего вещества в инфицированных тканях (многократно превышающих тканевые значения9), что в случае концентрационно-зависимого антибиотика (азитромицина) определяет скорость гибели бактериальных агентов. Полная эрадикация возбудителя в короткие сроки, зарегистрированная после исследования проб мочи, в некоторой степени также определяется достижимыми концентрациями, но в большей степени отражает наличие выраженного постантибиотического эффекта, пролонгирующего подавление бактериального роста. Положительная динамика в анализах мочи является следствием нивелирования поражающих факторов (антибактериальная активность препарата) и восстановления локального иммунитета (противовоспалительная активность) структурных элементов мочевыделительной системы собак и кошек.
Заключение
По итогам проведенной работы установлено, что пероральное введение препарата «Азитронит Солютаб» в дозе 10 мг/кг массы тела по ДВ демонстрирует 100%-ную эффективность при антибактериальной терапии собак и кошек с патологиями органов мочевыделения бактериальной этиологии. Терапевтический эффект и выздоровление установлены в клинических случаях при монобактериальных инфекциях, а также при сочетанной культуральной контаминации органов мочевыделительной системы у собак и кошек. Следует отметить отсутствие негативных реакций у животных при применении препарата и быструю динамику выздоровления (нормализацию клинического состояния).Таким образом, препарат «Азитронит Солютаб» является альтернативным выбором для лечения инфекций мочевыводящих путей у собак и кошек благодаря короткому курсу применения, широкому спектру антибактериального действия и высокой безопасности. Доказанная 100%-ная эффективность препарата в данном исследовании полностью соответствует фармакологическому профилю азитромицина и подтверждает его преимущества перед некоторыми традиционно применяемыми антибиотиками.
Список литературы:
- Касимова Д. Б. и др. Азитромицин – современный макролид, его фармакокинетика и известные методы анализа // Ташкентский фармацевтический институт // Ўзбекистон фармацевтик Хабарномаси. – с. 65.
- Лазарева М. В., Шкиль Н. А. Эпизоотология и совершенствование средств и методов лечения урогенитального микоплазмоза собак // Вестник НГАУ (Новосибирский государственный аграрный университет). – 2016. – № 2. – С. 108–115.
- Морозова Н. В. Биологические свойства микроорганизмов, выделенных из мочи собак при патологии мочевыделительной системы // Известия Оренбургского государственного аграрного университета. – 2020. – № 4 (84). – С. 206–208.
- Овчинников Р. С., Маноян М. Г., Гайнуллина А. Г. Грибковые и бактериальные инфекции мочевыделительной системы мелких домашних животных // Vetpharma. – 2013. – № 2 (13). – С. 24–30.
- Синк К. А., Вейнштейн Н. М. Общий анализ мочи в ветеринарной медицине. / Пер. с англ. Е. Поляковой. – М.: «Аквариум Принт», 2016. – 168 с.
- Синопальников А. И., Андреева И. В., Стецюк О. У. Безопасность макролидных антибиотиков: критический анализ // Клиническая медицина. – 2012. – Т. 90. – № 3. – С. 23–30.
- Drew R. H., Gallis H. A. Azithromycin-spectrum of activity, pharmacokinetics and clinical application. Pharmacother, 12: 161–73, 1992.
- Gordillo M. E., Singh K. V., Murray B. E. In vitro activity of azithromycin against bacterial enteric pathogens. Antimicrob Agents Chemother, 37: 1203, 1993.
- Hunter R. P., Lynch M. J., Ericson J. F., Millas W. J.,et al. Pharmacokinetics, oral bioavailability and tissue distribution of azithromycin in cats. . J. Vet Pharmacology and Therapeutics,18(1): 38–46, 1995
- Mayer-Roenne B., Goldstein R. E., Erb H. N. Urinary tract infections in cats with hyperthyroidism, diabetes mellitus and chronic kidney disease //Journal of feline medicine and surgery. – 2007. – Т. 9. – № 2. – С. 124–132.
- MVetClinStud C. O. B. B. V. S. H. Rational antibiotic therapy in an age of antibiotic resistance // Phuket.
- Owen W. M. A. et al. Efficacy of azithromycin for the treatment of feline chlamydophilosis // Journal of Feline Medicine and Surgery. – 2003. – Т. 5. – № 6. – С. 305–311.
- Rakhimzhanova D. T., Juman A., Aldabergenova A. Распространенность болезней мочевыводящих путей у кошек // Herald of science of S. Seifullin Kazakh agrotechnical university: Multidisciplinary. – 2022. – № 1 (112). – С. 279–288.
- Richard M. Shepard, Fred C. Falkner, Pharmacokinetics of azithromycin in rats and dogs. Journal of Antimicrobial Chemotherapy, Volume 25, Issue suppl_A, pages 49–60, 1990.
- Sunilchandra U. et al. Comparative efficacy of azithromycin and levofloxacin in pyoderma of dogs, 2015.
- White J. D. et al. Urinary tract infections in cats with chronic kidney disease // Journal of feline medicine and surgery. – 2013. – Т. 15. – № 6. – С. 459–465.

vetpeterburg
vetpeterburg Ветеринарный Петербург
Ветеринарный Петербург